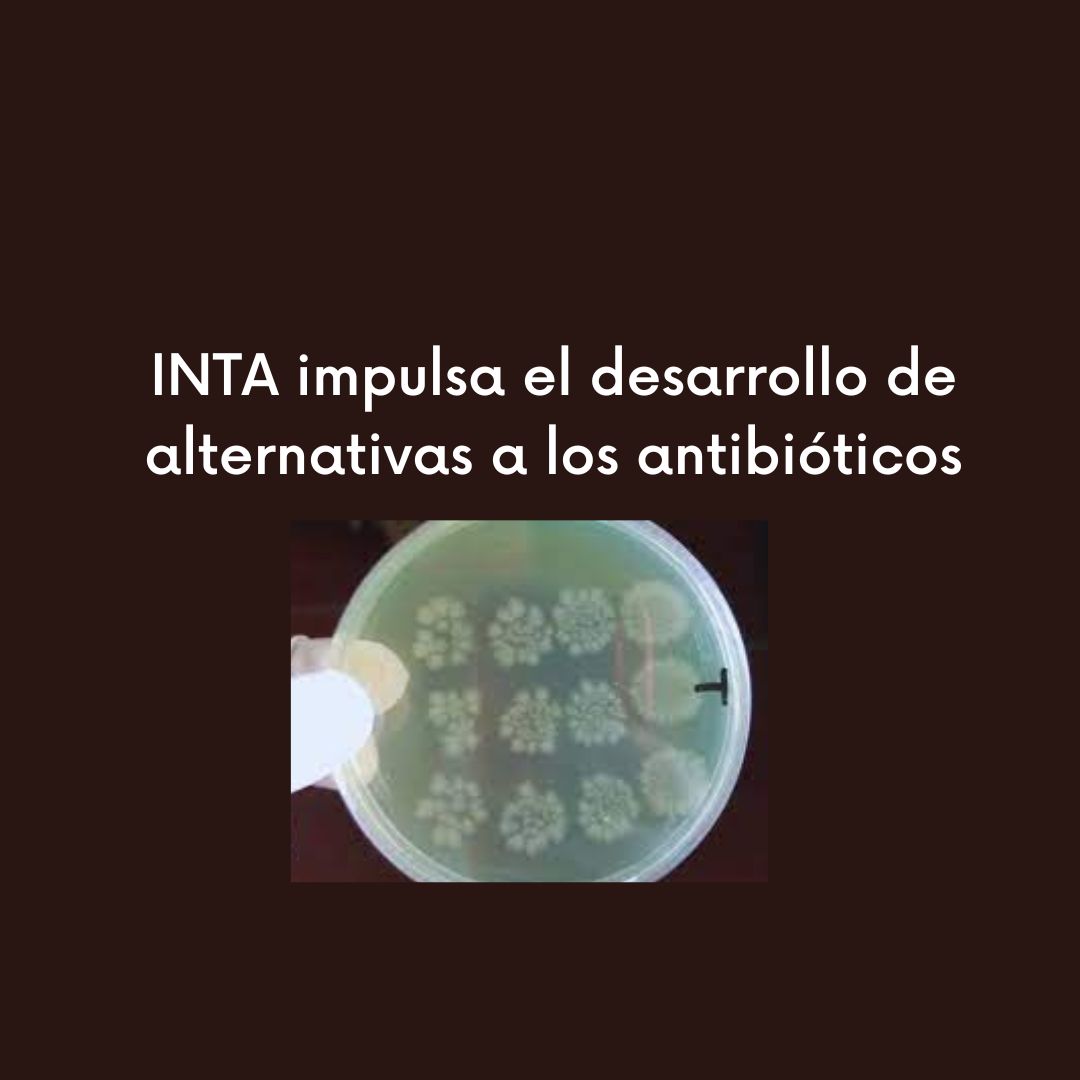

En el marco de la Semana de la Concientización sobre la Resistencia Antimicrobiana (RAM), desde el Centro de Investigación en Ciencias Veterinarias y Agronómicas (CICVyA) del INTA avanzan en el desarrollo de insumos basados en bacterias y derivados, como enzimas, compuestos nanotecnológicos, fitoquímicos, péptidos, vacunas e inmunoglobulinas para evitar el uso innecesario de antimicrobianos en la producción animal.
La Resistencia Antimicrobiana (RAM) es la capacidad de los microorganismos de producir mecanismos específicos que les permiten sobrevivir a las sustancias nocivas para su desarrollo como son los antimicrobianos. Dentro de estas sustancias, se incluyen los antibióticos, antiparasitarios, antimicóticos y antivirales. Para generar conciencia acerca de la gravedad de este fenómeno, desde el año 2015 la Semana Mundial de Concientización sobre la RAM es impulsada por las organizaciones mundiales de Sanidad Animal (OMSA), y de la Salud (OMS), y de las Naciones Unidas para la Alimentación y la Agricultura (FAO). Este año, además, se suma el Programa de las Naciones Unidas para el Medio Ambiente (UNEP).
“El peligro que conlleva el desarrollo y esparcimiento de la resistencia antimicrobiana es que los medicamentos se vuelven ineficaces para controlar las infecciones en las personas y los animales, con lo que también se incrementa el riesgo de propagación de estas enfermedades a otras personas o animales”, explicó Mariano Fernández Miyakawa, del Instituto de Patobiología Veterinaria (IPVET) del Centro de Investigación en Ciencias Veterinarias y Agronómicas (CICVyA) del INTA, quien coordina un proyecto de investigación con ese marco dentro del Programa Nacional de Salud Animal.
El INTA no solo genera información sobre la resistencia en microorganismos que circulan en los sistemas productivos y la eficacia de las drogas utilizadas para su control, la cual es importante en la toma de decisiones productivas y de salud, sino también en el desarrollo de tecnologías alternativas frente al uso indiscriminado de antiparasitarios y sus formas de resistencia para evitar el uso innecesario de estas formulaciones veterinarias en la producción animal.
“Dentro de esta, el desarrollo de productos alternativos a los antibióticos (antimicrobianos) ocupa una parte importante de los esfuerzos. Sin embargo, fundamental es la estrategia y el esfuerzo del INTA en la concientización sobre la temática en los sectores que aborda como así también el acompañamiento desde los sectores de la producción animal hacia un nuevo escenario de mayor restricción de uso de antimicrobianos”, señaló Fernández Miyakawa. Y agregó: “El tema actualmente se toca en forma directa como proyecto disciplinario sobre resistencia antimicrobiana y desarrollo de alternativas que forma parte del Programa Nacional de Salud Animal del INTA”.
En cuanto al reemplazo o complementación del uso de los antibióticos, “se encuentran en diferentes fases de desarrollo, productos basados en bacterias y sus productos, como enzimas, compuestos nanotecnológicos, fitoquímicos, péptidos, vacunas e inmunoglobulinas”, puntualizó Fernández Miyakawa. A su vez, señaló: “Existen desarrollos que tienen foco en cómo manejar los residuos para evitar el impacto ambiental que puedan tener los microorganismos y los genes asociados a la resistencia a los antimicrobianos”.
Durante los últimos años, el INTA priorizó esta temática como eje de su trabajo en el contexto de "Una Salud" dadas las implicancias que tiene en el desarrollo productivo, en la salud humana y en el ambiente, en sintonía con la preocupación que se tiene a nivel mundial. El organismo participa activamente en la toma de decisiones y planificación que realiza la Comisión Nacional de Control de la Resistencia Antimicrobiana (CoNaCRA), que tiene la responsabilidad de verificar el cumplimiento de la estrategia nacional para el control de la resistencia antimicrobiana. Además, el Programa de Salud Animal del INTA participó recientemente en Costa Rica junto a instituciones diversas de una reunión de expertos a través de una representación como IICA y USDA (Una Salud en las Américas: La importancia de la colaboración interinstitucional en el hemisferio y sus comunidades rurales, 2023) donde se discutieron aspectos de la situación de los países del Norte, Centro y Sud América y posibles desarrollos de estrategias que mitiguen el uso de antimicrobianos así como concientizar sobre su perjuicio desde Una Salud.
En el organismo, existen varios grupos de investigación que estudian el desarrollo y la aplicación de moléculas, productos y estrategias para reducir el uso de antimicrobianos. “Podemos mencionar los antiparasitarios, en el que la resistencia representa un gran problema productivo, existiendo grupos que trabajan en diferentes compuestos fitoquímicos para poder evitar el desarrollo de resistencia”, señaló el investigador.
En línea con el especialista, “el INTA realiza diversas tareas de comunicación sobre la problemática de la resistencia y como poder mejorar la problemática: una de estas formas es directa, con los productores en todo el país, dependiendo de cada región y las cadenas productivas más representativas, tanto en charlas como en asesoramiento”. También se realiza mediante laboratorios y empresas que brindan servicios a los productores, brindándoles capacitación y charlas para concientizar sobre la problemática, pero también acompañando en la transición al uso de alternativas, promoviendo el mantenimiento o mejora de los niveles productivos y la sustentabilidad ambiental.
La Argentina es uno de los pocos países que tiene una ley específica en la temática, la que se reglamentó este año, conocida como la Ley de Prevención y Control de la Resistencia a los Antimicrobianos. Esta ley enmarca toda la problemática de la resistencia y las acciones para su control.
Para concluir, Fernández Miyakawa indicó que “los principales desafíos del sector de producción animal es poder reducir el uso de antimicrobianos y mantener o incrementar la eficiencia productiva”.
En un contexto en el que los microorganismos se vuelven más resistentes, “el uso prudente y estratégico es fundamental, como así también el uso de alternativas a los antimicrobianos”. En este contexto, todo lo que implique mejoras en la salud animal impacta positivamente en la disminución del uso de antimicrobianos.
Fuente: INTA
TAGS: INTA. Antimicrobianos. Resistencia Antimicrobiana. Semana Mundial de Concientización sobre la RAM. Salud. Una Salud. One Health

No hay comentarios aún.